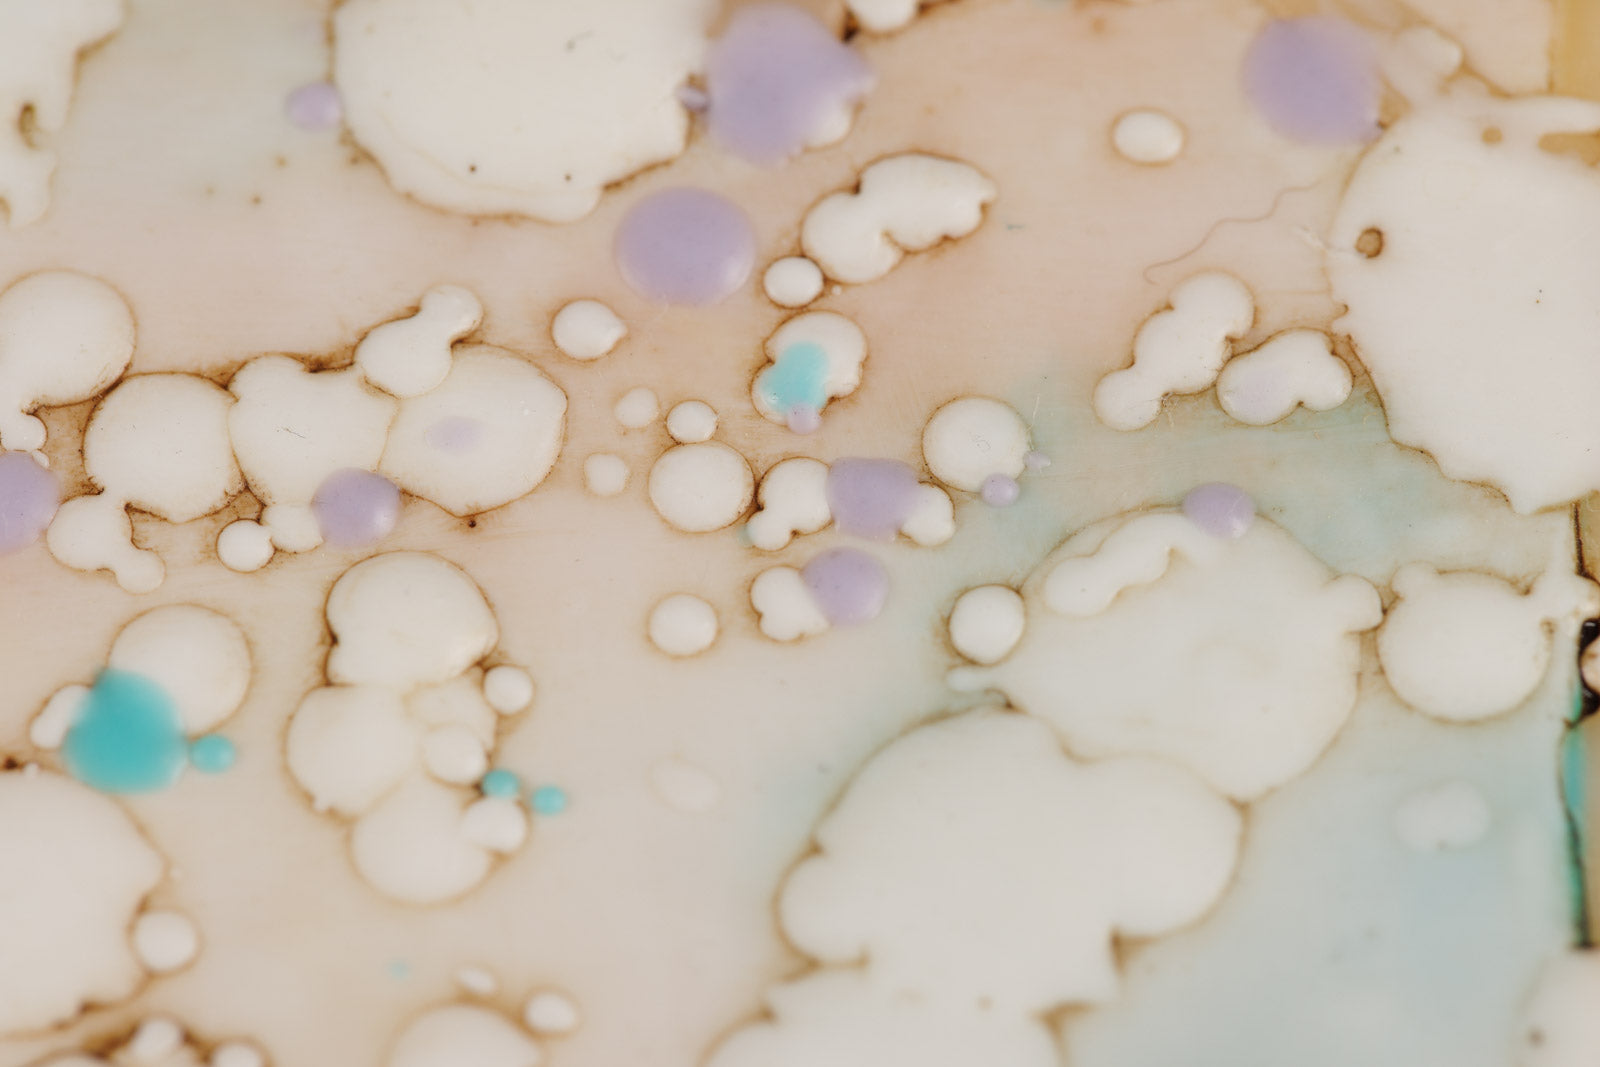

Staycation
Encaustic on Panel
Unframed - Gallery Panel 2” Deep - Finished Wood Edge
art size / 30" x 10"
Choose options








Staycation
Sale price950 CAD










Encaustic on Panel
Unframed - Gallery Panel 2” Deep - Finished Wood Edge
art size / 30" x 10"
Choose options